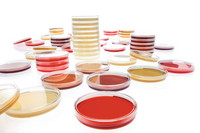

R3A Agar – LI 30ml 20PC Merck
0 ₫
R3A Agar – LI 30ml sản xuất bởi hãng Merck Đức, code: 1460740020, tồn tại dưới dạng rắn, màu trắng ngà. Được sử dụng để phân lập sơ cấp các vi sinh vật thủy sinh. Quy cách đóng gói: 20 tấm/ hộp
| Tên sản phẩm: | R3A Agar – LI 30ml 20PC Merck |
| Tên gọi khác: | Reasoner’s 3A agar |
| Code: | 1460740020 |
| Hãng- Xuất sứ: | Merck Đức |
| Ứng dụng: |
– Được sử dụng để phân lập sơ cấp các vi sinh vật thủy sinh – Nuôi cấy vi snh vật |
| Tính chất: |
– Dạng: rắn – Màu: màu trắng ngà – Gía trị pH: 7.2 (H₂O) |
| Bảo quản: | Từ +15°C đến +25°C |
| Quy cách đóng gói: | 20 tấm/ hộp |
Hãy là người đầu tiên nhận xét “R3A Agar – LI 30ml 20PC Merck” Hủy
Sản phẩm tương tự
Hóa chất thí nghiệm
Cal Check chuẩn Clo dư và Clo tổng, 0.00 và 1.00 mg/l HI93414-11 Hanna
Hóa chất thí nghiệm
CAL Check™ Chuẩn Độ Cứng Tổng: 0, 150, 350 và 520 mg/L CaCO3 HI96735-11 Hanna
Hóa chất thí nghiệm
Hóa chất thí nghiệm
Hóa chất thí nghiệm
Hóa chất thí nghiệm
CAL Check™ chuẩn Amoni thang trung, 0.0 và 6.0 mg/L HI96715-11 Hanna
Hóa chất thí nghiệm
Hóa chất thí nghiệm
Potassium iodate solution for 1000 ml, c(KIO₃) = 1/₆₀ mol/l (0.1 N) Titrisol®

Đánh giá
Chưa có đánh giá nào.